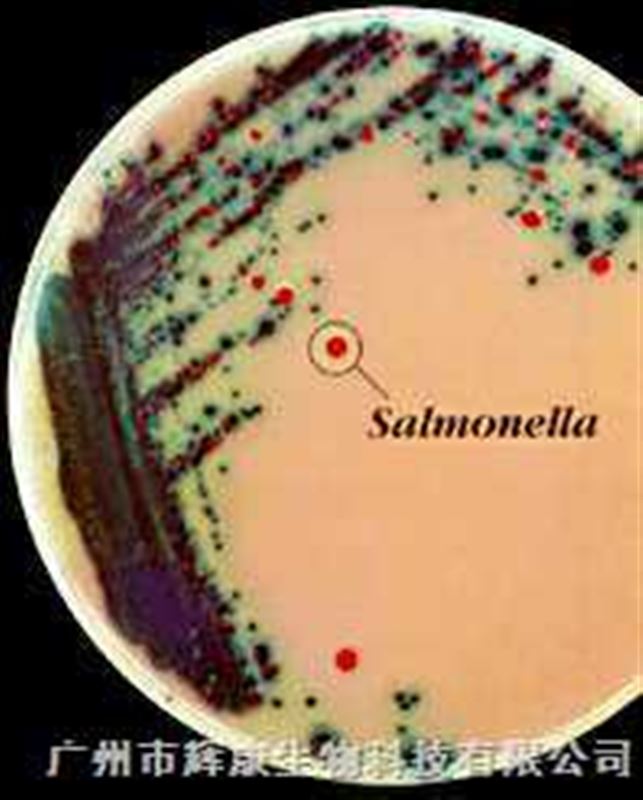

服务热线:13503016093产品到哪里,服务到哪里 !

厂商性质:生产厂家
厂商性质:生产厂家 产品地址:广州市
产品地址:广州市 更新时间:2025-08-06
更新时间:2025-08-06 浏览次数:2499
浏览次数:2499 立即咨询
立即咨询
 联系电话:13503016093
联系电话:13503016093
产品说明:用于分离沙门氏菌属,用于鉴别包括伤寒杆菌在内的沙门氏菌
| 序号 | 品名 | 规格 | 用途 |
| 1 | 念珠菌显色培养基 | 1000ml | 用于分离和鉴定主要致病性念球菌 |
| 25000ml | |||
| 2 | 定位显色培养基 | 1000ml | 用于尿道细菌的分离和鉴别,也可用于伤口感染标本的病原菌分离 |
| 25000ml | |||
| 3 | 沙门氏菌显色培养基 | 1000ml | 用于鉴别包括伤寒杆菌在内的沙门氏菌 |
| 25000ml | |||
| 4 | 大肠杆菌显色培养基 | 1000ml | 用于大肠杆菌的鉴定和计数 |
| 25000ml | |||
| 5 | ECC显色培养基 | 1000ml | 用于大肠杆菌和大肠菌群的鉴定和计数 |
| 25000ml | |||
| 6 | O157菌显色培养基 | 1000ml | 用于大肠杆菌O157的分离和鉴定 |
| 25000ml | |||
| 7 | 改良O157菌显色培养基 | 1000ml | 用于大肠杆菌O157的分离和鉴定 |
| 25000ml | |||
| 8 | 金黄色葡萄球菌显色培养基 | 500ml | 用于金黄色葡萄球菌的鉴定和计数 |
| 1000ml | |||
| 5000ml | |||
| 9 | MRSA显色培养基 | 1000ml | 用于耐甲氧西林金黄色葡萄球菌的分离和鉴定 |
| 5000ml | |||
| 10 | 李斯特菌显色培养基 | 1000ml | 用于产单核李斯特菌的分离和鉴定 |
| 5000ml | |||
| 11 | 弧菌显色培养基 | 1000ml | 用于霍乱弧菌、副溶血弧菌的分离和鉴别 |
| 5000ml | |||
| 12 | 念珠菌显色培养基 | 70mm | 用于分离和鉴定主要致病性念球菌 |
| 90mm | |||
| 13 | 定位显色培养基 | 70mm | 用于尿道细菌的分离和鉴别,也可用于伤口感染标本的病原菌分离 |
| 90mm | |||
| 14 | 沙门氏菌显色培养基 | 70mm | 用于鉴别包括伤寒杆菌在内的沙门氏菌 |
| 90mm | |||
| 15 | 大肠杆菌显色培养基 | 70mm | 用于大肠杆菌的鉴定和计数 |
| 90mm | |||
| 16 | ECC显色培养基 | 70mm | 用于大肠杆菌和大肠菌群的鉴定和计数 |
| 90mm | |||
| 17 | O157菌显色培养基 | 70mm | 用于大肠杆菌O157的分离和鉴定 |
| 90mm | |||
| 18 | 改良O157菌显色培养基 | 70mm | 用于大肠杆菌O157的分离和鉴定 |
| 90mm | |||
| 19 | 金黄色葡萄球菌显色培养基 | 70mm | 用于金黄色葡萄球菌的鉴定和计数 |
| 90mm | |||
| 20 | 李斯特菌显色培养基 | 70mm | 用于产单核李斯特菌的分离和鉴定 |
| 90mm | |||
| 21 | 弧菌显色培养基 | 70mm | 用于霍乱弧菌、副溶血弧菌的分离和鉴别 |

返回列表